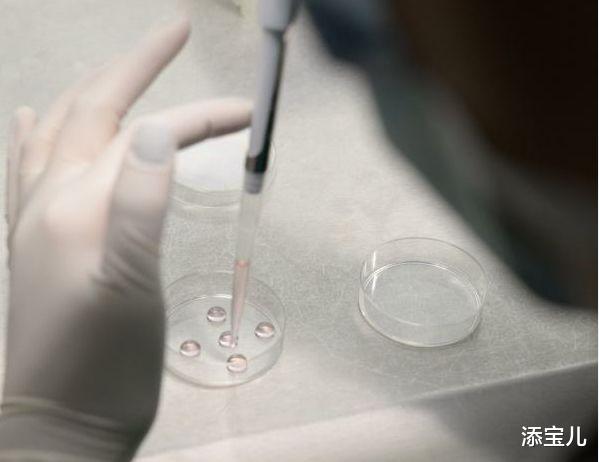
添宝儿|试管婴儿过程中监测卵泡有多关键?

添宝儿|试管婴儿过程中监测卵泡有多关键?

文章图片

文章图片

文章图片

文章图片
大家都知道 , 正常育龄女性每个月经周期会排出一个成熟的优势卵泡 。 可以说 , 卵泡发育质量决定生育质量 。
在试管婴儿孕育宝宝的过程中 , 影响试管婴儿成功率的一个关键因素就是获得优质的卵子 , 监测卵泡发育对此有关键意义 。
卵泡是什么?为什么要监测卵泡?
卵泡是在卵巢皮质内由一个卵母细胞以及其周围许多小型卵泡细胞所组成 。
根据卵泡发育过程的形态以及功能变化 , 可分为原始卵泡、生长卵泡以及成熟卵泡三个阶段 。
“卵巢”最关键的功能是产生“卵子” , 卵子在卵泡里和卵泡同步成熟 , 发育良好的卵子是试管婴儿成功的保障 。
但是卵子太小 , 肉眼看不见 , 在试管婴儿中 , 为了成功取到优质的卵子配成胚胎 , 只能间接地通过观察卵泡来推测卵子的发育状况 。
卵泡发育最简单、最直观的评估是通过超声观察 , 每个周期通过3-4次的超声监测 , 能够观察到有没有正常的卵泡生长、发育、以及何时可进行取卵手术 。
试管婴儿中卵泡监测有多关键?
在试管婴儿促排卵过程中 , 卵泡监测是为了评价卵巢刺激的效果以及决定取卵的时间 。
当一个或一个以上卵泡直径大于18mm , 或者三个或三个以上卵泡直径大于16mm时 , 便可当日“打夜针”注射人绒毛如性腺激素(HCG) , 促使卵泡成熟 。
在注射HCG后36小时取卵 。
成熟卵泡圆而饱满 , 内壁薄而清晰 , 有张力 。 卵泡数量太少有可能取不到卵子 , 如小于两个卵泡应放弃 , 但也不是越多越好 , 卵泡数量过多 , 要警惕卵巢过度刺激综合征的发生 。
每个人对促排卵药的反应也不一样 , 有的人卵泡前期长得慢 , 也不用过于担心 , 专家也会根据个人状况不一样调整药物的 。
试管婴儿中卵泡监测是怎样进行的?
监测卵泡的时间 , 专家会根据病人的身体状况而定 。
监测期间 , 专家通过B超 , 能够发现以及了解诱发生长的卵泡数目、大小 , 然后根据监测的结果来适当调整促排卵药的剂量以及用药时间 。
通常说来 , 月经周期第10-12天时 , 优势卵泡数量就能够达到2-3个 , 能够发育到40px大小 , 不过此时并不能急于取卵 , 要根据子宫内膜的厚度 , 尿LH峰 , 来决定注射HCG时间 。
因为每个人体质存在差异 , 对促排卵药物的反应不一 , 所以专家会通过监测卵泡发育状况确定取卵的时间 。
【添宝儿|试管婴儿过程中监测卵泡有多关键?】
- 宝宝一岁前,辅食怎么添加?家长应参照正确做法,别乱来伤到宝宝
- 第三代试管婴儿PGT筛查有哪些优点和缺点?
- 华南虎|奶凶奶凶!洛阳王城公园新添的两只华南虎小虎崽有望春节期间“会客”
- 宝宝辅食添加不当,会影响孩子身高智力语言发育,妈妈要重视
- 试管婴儿四代技术的前世今生!
- 宝宝辅食添加顺序有讲究,最先补充的营养元素是它
- [育儿知识]各月龄敏宝辅食添加食谱,宝妈别再给孩子吃错了
- 妈妈|当年不听劝阻,执意做试管婴儿的“无腿妈妈”,生活现状让人动容
- 宝宝添加辅食的时间,别卡在6个月,观察“3动1值”更准确
- 孙巳|2022、2023年添丁添喜,家运昌隆的生肖